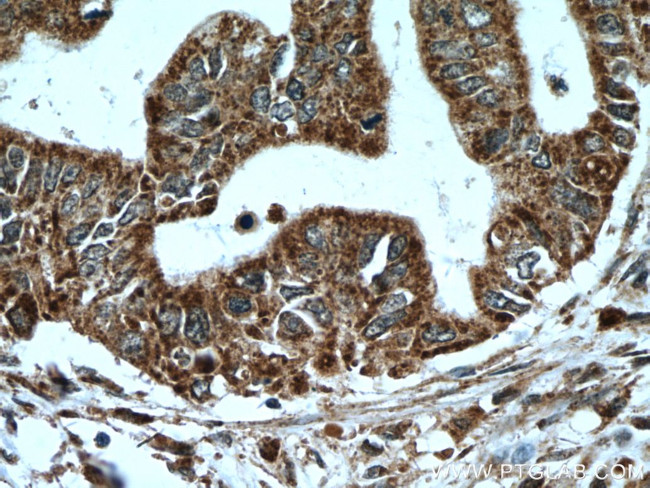
A4GNT Antibody in Immunohistochemistry (Paraffin) (IHC (P))
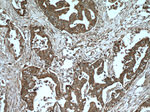
A4GNT Antibody in Immunohistochemistry (Paraffin) (IHC (P))
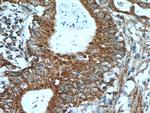
A4GNT Antibody in Immunohistochemistry (Paraffin) (IHC (P))
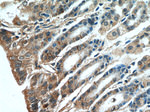
A4GNT Antibody in Immunohistochemistry (Paraffin) (IHC (P))

Search
Proteintech
A4GNT Polyclonal Antibody
{{$productOrderCtrl.translations['antibody.pdp.commerceCard.promotion.promotions']}}
{{$productOrderCtrl.translations['antibody.pdp.commerceCard.promotion.viewpromo']}}
{{$productOrderCtrl.translations['antibody.pdp.commerceCard.promotion.promocode']}}: {{promo.promoCode}} {{promo.promoTitle}} {{promo.promoDescription}}. {{$productOrderCtrl.translations['antibody.pdp.commerceCard.promotion.learnmore']}}
产品信息
22670-1-AP
种属反应
宿主/亚型
分类
类型
抗原
偶联物
形式
浓度
规格
纯化类型
保存液
内含物
保存条件
运输条件
产品详细信息
Immunogen sequence: KIYPEWPVV FFMKGLTDST PMPSNSTYPA FSFLSAIDNV FLFPLDMKRL LEDTPLFSWY NQINASAERN WLHISSDASR LAIIWKYGGI YMDTDVISIR PIPEENFLAA QASRYSSNGI FGFLPHHPFL WECMENFVEH YNSDIWGNQG PELMTRMLRV WCKLEDFQEV SDLRCLNISF LHPQRFYPIS YREWRRYYEV WDTEPSFNVS YALHLWNHMN QEGRAVIRGS NTLVENLYRK HCPRTYRDLI KGPEGSVTGE LGPGNK (76-340 aa encoded by BC119639)
靶标信息
This gene encodes a protein from the glycosyltransferase 32 family. The enzyme catalyzes the transfer of N-acetylglucosamine to core 2 branched O-glycans. It forms a unique glycan, GlcNAcalpha1->4Galbeta->R and is largely associated with the Golgi apparatus membrane.
仅用于科研。不用于诊断过程。未经明确授权不得转售。
篇参考文献 (0)
生物信息学
蛋白别名: Alpha-1,4-N-acetylglucosaminyltransferase; alpha4 GnT; Alpha4GnT; glycosyltransferase; GnTalpha4; MGC149493
基因别名: A4GNT; Alpha4gnt; AV080780; Gm798
UniProt ID: (Human) Q9UNA3, (Mouse) Q14BT6
Entrez Gene ID: (Human) 51146, (Rat) 685758, (Mouse) 333424